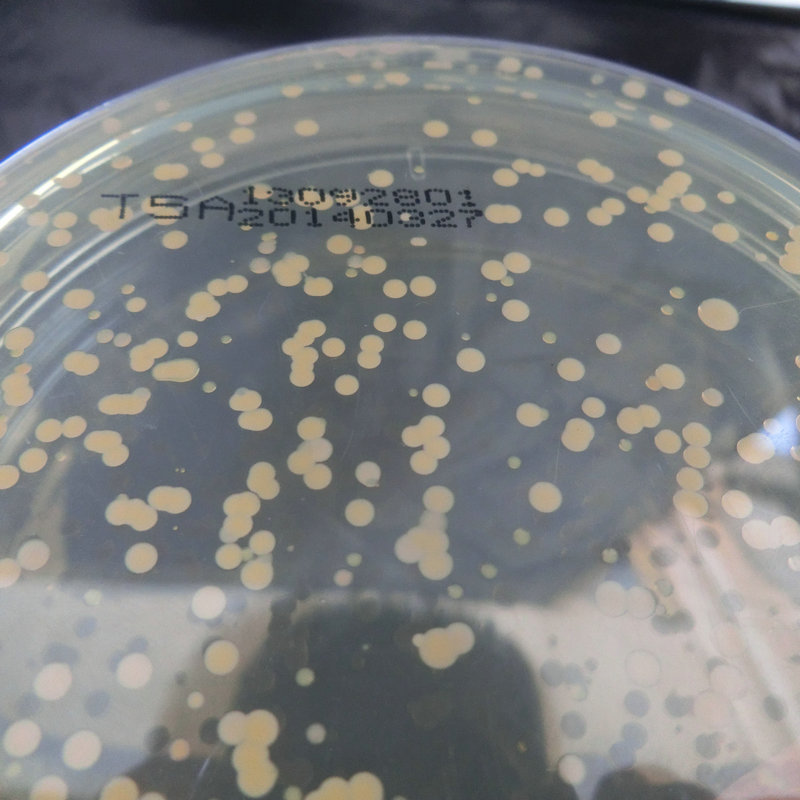
TSA表面接触皿 大豆酪蛋白琼脂表面培养基 三层真空袋包装

1688工业品为您提供在线免费查询更多化学试剂详细参数、实时报价、规格一览表。更多关于化学试剂多少钱一瓶/化学试剂报价明细/化学试剂规格型号价格表/化学试剂批发市场价格/化学试剂官方报价等咨询,尽在1688工业品。询底价>
为你找到生化试剂相关产品
TSA表面接触皿 大豆酪蛋白琼脂表面培养基 三层真空袋包装
江苏南京
在线询价

PPLO琼脂 PPLO Agar HB8475-1 250g 青岛海博生物
山东青岛
在线询价

GBW07480三江源土壤成分分析标准物质30g 带证书 土壤标准物质
湖北武汉
在线询价

供应 硫氰酸胍 异硫氰酸胍 CAS:593-84-0 实验装
山东济南
在线询价

微晶纤维素(纤维素) 100g/500g,科研用 CAS:9004-34-6
北京
在线询价

焦磷酸钾/7320-34-5/源叶 S11152/Potassium pyrophosphate/AR,9
上海
在线询价

雷公藤次碱/11088-09-8/源叶 B20705/Wilforine/HPLC≥98% 标准品
上海
在线询价

科研试剂 聚丙烯酸树脂Ⅲ 级别:BR 现货 可开发票
江苏南京
在线询价

偏钒酸钠二水 / 钒酸钠二水 / 16519-65-6
上海
在线询价

N-(2-羟乙基)哌嗪-N-2-羟基丙磺酸, 68399-78-0,科研用实验试剂
河北保定
在线询价

Qiagen 51304 基因组DNA小提试剂盒,50T/盒
北京
在线询价

K106582P Anti-HSP60 Polyclonal Antibody多克隆抗体 抗体 多抗
北京
在线询价
查看更多产品及报价
100+生化试剂相关产品等你解锁
在线寻源3000行家正在找货
免费询价,源头正品,上1688工业品,全国的工业正品交易平台





